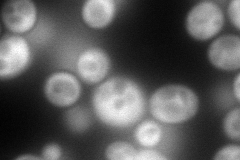
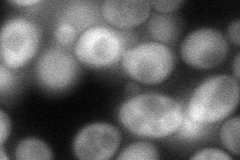
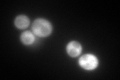
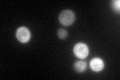

View description
Pyruvate carboxylase isoform, cytoplasmic enzyme that converts pyruvate to oxaloacetate; highly similar to isoform Pyc2p but differentially regulated; mutations in the human homolog are associated with lactic acidosis
Localization:
Intensity:
Fold change:
Significance:
-
C’ GFP library in SD

cytosol167.18 -
N' NOP1pr-GFP in SD
cytosol245.3 -
N' TEF2pr-mCherry in SD

cytosol199.169 -
N' NATIVEpr-GFP in SD

cytosol29.0926 -
N' TEF2pr-VC and Cyto-VN in SD
cytosol83.5598 -
C’ GFP library in SD+DTT
cytosol245.531.46Yes -
C’ GFP library in SD+H2O2

cytosol210.821.26No -
C’ GFP library in Starvation Media
cytosol174.971.04No -
C’ GFP library on the background of Pup2-DaMP

cytosol -
C’ GFP library on the background of CCT mutant

cytosol171.3771.02502No
